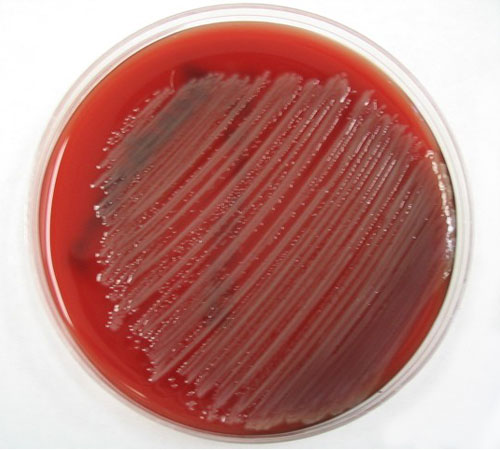
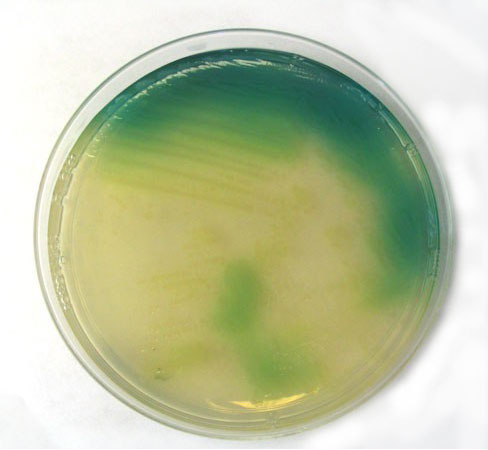

Hello Hello,
Spring is in the air, and I hope you're enjoying the nicer weather. This month we have an article about Pseudomonas aeruginosa by Murali Putty. I hope you'll find this article interesting and helpful.
With best wishes,
Dave Gallup
Pseudomonas Aeruginosa
By Murali Putty, EMLab™ Analyst
Pseudomonas aeruginosa is a gram-negative, aerobic rod measuring 0.5 to 0.8 µm belonging to the bacterial family Pseudomonadaceae. Like other Pseudomonads, P. aeruginosa secretes a variety of pigments, including pyocyanin (blue-green), fluorescein (yellow-green and fluorescent), and pyorubin (red-brown). P. aeruginosa is often preliminarily identified by its pearlescent appearance and grape-like odor in vitro.
Pseudomonas aeruginosa is widespread in nature, inhabiting soil, water, plants and animals (including humans). Identification of P. aeruginosa often includes identifying the production of both pyocyanin and fluorescein. Its optimum temperature for growth is 37°C, and it is able to grow at temperatures as high as 42°C. Pseudomonas aeruginosa has very simple nutritional requirements. It is often observed "growing in distilled water" which is evidence of its minimal nutritional needs. It is tolerant to a wide variety of physical conditions. P. aeruginosa is capable of growth in diesel and jet fuel, where it is known as a hydrocarbon utilizing microorganism (or "HUM bug"), causing microbial corrosion. It is resistant to high concentrations of salts and dyes, weak antiseptics, and many commonly used antibiotics. These natural properties of the bacterium undoubtedly contribute to its ecological success.
Figure 1: Pseudomonas aeruginosa on Trypic Soy Agar (TSA).
Copyright © 2007 Environmental Microbiology Laboratory, Inc.
Pseudomonas aeruginosa is an opportunistic pathogen, causing urinary tract infections, respiratory system infections, dermatitis, soft tissue infections, bacteremia, bone and joint infections, gastrointestinal infections and a variety of systemic infections, particularly in patients with severe burns and in cancer and AIDS patients who are immunosuppressed. Pseudomonas aeruginosa is primarily a nosocomial pathogen; its infection is a serious problem in patients hospitalized with cancer, cystic fibrosis and burns. The case fatality rate in these patients is 50 percent. According to the Centers for Disease Control (CDC), the overall incidence of P. aeruginosa infections in the US hospitals averages 0.4 percent (4 per 1000 discharges), and the bacterium is the fourth most commonly isolated nosocomial pathogen accounting for 10.1 percent of all hospital-acquired infections. The most commonly encountered infection outside hospitals is otitis externa ("Swimmer's ear"), of which P. aeruginosa causes 35-70%. They also cause eye infections ranging from perulent conjunctivitis to iridocyclitis, keratitis and iritis, corneal ulcer and panophthamitis. It is also a cause of "hot-tub rash" (dermatitis), caused by lack of proper, periodic attention to water quality.
Figure 2: Pseudomonas aeruginosa in Pseudomonas Isolation Agar.
Copyright © 2007 Environmental Microbiology Laboratory, Inc.
P. aeruginosa isolates may produce three colony types. Natural isolates from soil or water typically produce a small, rough colony. Clinical samples, in general, yield one or another of two smooth colony types. One type has a fried-egg appearance, which is large,
smooth, with flat edges and an elevated appearance. Another type, frequently obtained from respiratory and urinary tract secretions, has a mucoid appearance, which is attributed to the production of alginate slime. The smooth and mucoid colonies are presumed to play a role in colonization and virulence.
Like most environmental bacteria, P. aerugionosa lives predominantly in slime-enclosed biofilms adherent to available surface from which it periodically releases (free-swimming) cells. Most Pseudomonas infections are both invasive and toxinogenic. The ultimate Pseudomonas infection may be seen as composed of three distinct stages: (1) bacterial attachment and colonization; (2) local invasion; (3) disseminated systemic disease. The slime-protected cells of P. aeruginosa produce remarkably few clinical symptoms while they are in the process of progressively colonizing inert surfaces and tissue surfaces within the host. The lipopolysaccharide layer helps the cell adhere to host tissues and prevents leukocytes from ingesting and lysing the organism. Lipases and exotoxins then procede to destroy host cell tissue which then leads to the complications associated with infection.
Only a few antibiotics are effective against Pseudomonas, including fluoroquinolones, gentamicin and imipenem, and even these antibiotics are not effective against all strains. The best way to reduce the spread of P. aeruginosa is to use good aseptic technique especially on hospital instruments and when in contact with patients. The combination of gentamicin and carbenicillin is frequently used to treat severe Pseudomonas infections.
References:
1. Murray, P.R., E.J. Baron, M.A. Pfaller, F.C. Tenover & R.H.Yolken (eds) 1995. Manual of Clinical Microbiology, 6th edition, pp. 510-515, ASM, Washington, D.C.
2. Baltch, A.L and R. P. Smith (eds) (1994) Pseudomonas Aeruginosa: Infections and Treatment. Marcel Dekker, Inc., New York, NY.
3. Wikipedia
4. Pseudomonas Genome Database
5. Todar's Online Textbook of Bacteriology
6. Pseudomonas Aeruginosa Infections
7. Topics in Infectious Diseases Newsletter: August 2001